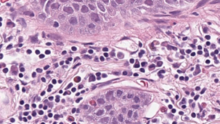

Xsphera supports drug development teams with end-to-end planning and analysis services that accelerate decision making. Our breakthrough ex vivo platform is a novel combination of processes and technology that allows deep exploration of human responses to drug therapies.




Our team has experience with a wide range of oncology therapeutics with different modalities and targets.
Biologics | Small Molecules | Targets |
|---|---|---|
Immune Checkpoint Modulators | Chemotherapies | Tumor cells |
Monoclonal Antibodies | Inhibitors | T-Cells |
Bi-Specific Antibodies | Degraders | NK Cells |
Cell Therapies | Combination Therapies | Tregs |
Oncolytic Viruses | Macrophages | |
Antibody Drug Conjugates | Neutrophils | |
MDSCs |
Qualified clinical sites with IRB approval across North America
|
|
|
|
|
|
|
|
|
Directly Assess Functional Response
Fresh tumor tissue is dissociated into spheroids and loaded with an ECM into separate microfluidic chambers. These chambers are then be treated with one or more treatments and allowed to proliferate in culture over several days. Fluorescent microscopy and AI-based automated image analysis is used to quantify changes in live and dead cells for all treatment arms. Response is then based on changes relative to the negative control arm.
Negative Control

Treatment

Treatment Response Assessed on 100’s of Spheroids
Spheroid % Dead Area

Patient Stratification
A range of clinical data and sample pre-treatment data can be collected to profile and correlate patient pre-treatment state with the ex vivo functional response. This information can then be used to develop predictive biomarkers.
Clinical Data
Tumor & Immune Profile

Histopathology
Integrated Cloud Analytics Platform
Lab data is automatically uploaded and integrated into your study database. Clients have transparent access and can analyze data as it is generated. The platform provides powerful data analysis and visualization capabilities leveraging AI/ML.

Contact our Team to Plan Your Study
Our team is here to support your team with study design, execution and analysis. We seamlessly integrate as an extension of your team, providing collaboration and transparency throughout the process.
© 2026 Xsphera Biosciences
26 Landsdowne Street
Cambridge, MA, 02319 — ALL RIGHTS RESERVED